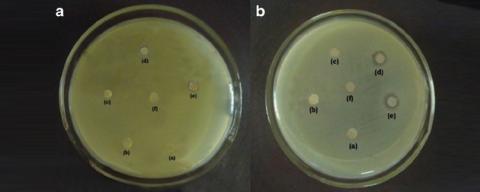
Biocide Antimicrobial an antimicrobial and preservative used in a wide variety of applications, such as bactericide for reverse osmosis water treatment.Application: Popular to used for reverse osmosis water treatment. Also Suitable for applications in the water-based polymer, leather, paint, textile, printing and dyeing, metal cutting fluids, adhesives, inks, dyes, dye dispersions industries to resist corrosion.

<p style="text-align: justify;">KENYA CHEMICAL is a world-famous manufacturer, supplier, and exporter of <a href="http://kenyachemical.com
kenya chemical is one of the leading Potassium bisulfate manufacturers, suppliers, exporters, producers, in kenya.
kenya chemical is one of the leading Monopotassium phosphite manufacturers, suppliers, exporters, producers, in kenya.
kenya chemical is one of the leading Monopotassium phosphate (MKP) manufacturers, suppliers, exporters, producers, in kenya.
kenya chemical is one of the leading Potassium iodide manufacturers, suppliers, exporters, producers, in kenya.
kenya chemical is one of the leading Potassium iodate (KIO3) manufacturers, suppliers, exporters, producers, in kenya.
kenya chemical is one of the leading Potassium periodate KIO4 manufacturers, suppliers, exporters, producers, in kenya.
kenya chemical is one of the leading Potassium permanganate KMnO4 manufacturers, suppliers, exporters, producers, in kenya.
kenya chemical is one of the leading Potassium nitrate KNO3 manufacturers, suppliers, exporters, producers, in kenya.
kenya chemical is one of the leading Potassium nitrite KNO2 manufacturers, suppliers, exporters, producers, in kenya.
kenya chemical is one of the leading Potassium carbonate K2CO3 manufacturers, suppliers, exporters, producers, in kenya.
kenya chemical is one of the leading Potassium manganate manufacturers, suppliers, exporters, producers, in kenya.